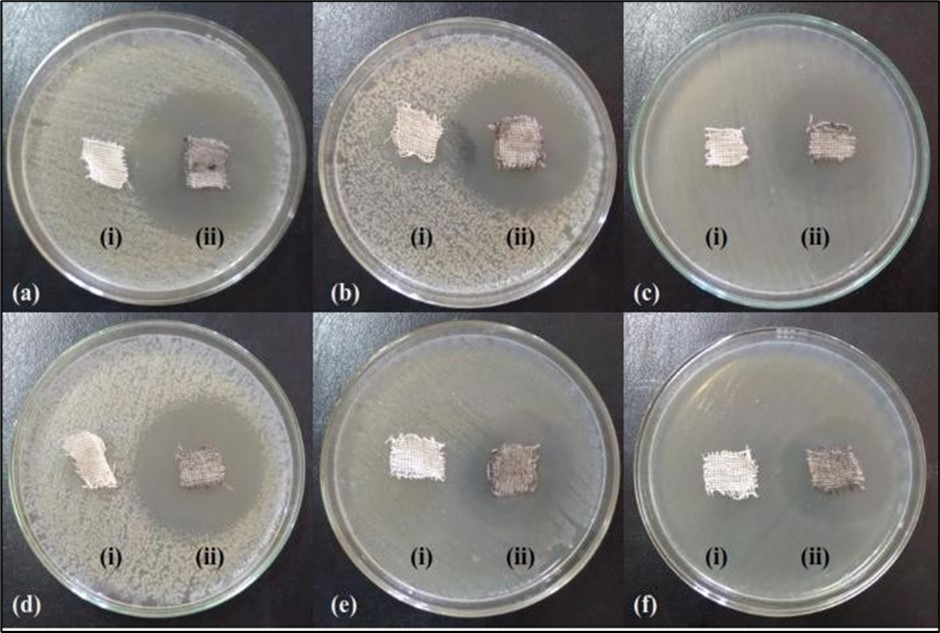

Antibacterial Activities of Ni Substituted Ferrite Particles for Biological Applications
Abstract
In this research work Mg0.45Mn0.55-xNixFe2O4 ferrite particles of varying compositions (x=0.05, x=0.15, x=0.25, x=0.45 and x=0.55) were synthesized using cost effectual co-precipitation route. The synthesized ferrite particles were characterized by collection of techniques. XRD analysis confirmed the formation of cubic spinel structure of the ferrite particles. SEM and AFM analyses illustrated the morphology and size distribution of obtained ferrite particles. FT-IR study exposed that the absence of any additional peak related to second phase. VSM results indicated magnetic analyses such as saturation magnetization (MS), Coercivity (HC) and Remanence (Mr) of ferrite particles. The major objective of the present investigation is to synthesize MgMnNiFe2O4 ferrite particles on cotton fabrics in order to obtain finished fabrics; it is very significant in biological applications. The antibacterial activities of the ferrite particles coated cotton fabrics were tested against selected Gram positive and Gram negative bacteria which showed tremendous results via formation of inhibition zones. The fabricated ferrite particles on cotton fabrics showed great durability evidenced by their antibacterial activities even after 20 washing cycles. Hence, the functionalized cotton fabrics could be used as potential antibacterial agent.
Author Contributions
Academic Editor: Jun Wan, Medical & Molecular Genetics, HS 5013 MMGE, Indianapolis.
Checked for plagiarism: Yes
Review by: Single-blind
Copyright © 2022 Subbiah Rammohan Chitra, et al.
This is an open-access article distributed under the terms of the Creative Commons Attribution License, which permits unrestricted use, distribution, and reproduction in any medium, provided the original author and source are credited.
Competing interests
The authors have declared that no competing interests exist.
Citation:
Introduction
Ferrite particles are relatively new materials which have a more effectual interaction with biological systems due to their high proportion of surface to volume ratio in comparison with bulk ones. This characteristic has ready them appropriate to be used in many medical and biological applications 1. Magnetic ferrite particles of iron oxides (Fe3O4 and Fe2O3) are now extensively used throughout the medicine, drug delivery, superparamagnetism, antimicrobial, non-toxicity, biocompatibility, biodegradability, chemical inertness properties 2, 3. Recently, it is investigated that nanoferrite particle can be applied in biomedical field due to its antibacterial properties 4. Natural textile fibers are more susceptible to microbial stabbing than the man-made fibers. Microbial enlargement on fabrics and other textile products becomes evident as surface changes, discoloration, and unpleasant odors 5. In recent years, the medical textile fabrics were subjected to antimicrobial finishes to avoid the possibility of infections arising owing to the presence of microorganisms. Since there is an incidence of emerging of antibiotic resistance among the bacterial strains, there is a need to discover new antimicrobial compounds with diverse chemical structures and mechanisms of action. In the present study dealt with the loading of the prepared ferrite particles on cotton fabrics by pad-dry- cure technique. Accordingly, the antimicrobial activities of the particles loaded cotton fabrics against elected clinically pathogenic bacteria along with wash durability were evaluated.
Experimental Procedure of The Prepared Ferrite Particles
The nanoferrite particles Mg0.45Mn0.55-xNix-Fe2O4 with the composition (x=0.05, x=0.15, x=0.25 and x=0.45) were prepared using hydrated sulfates of the constituent elements.
Materials
The starting materials for the preparation of these series were NaOH pellets (>99%, Merck, Mumbai, India), magnesium sulfate MgSO4.7H2O (>99%, Merck), manganese sulfate MnSO4.H2O (>98.5%, Merck), and nickel sulfate NiSO4.6H2O (>99%, Merck).
Glassware and Apparatus
All glass wares such as measuring cylinders, test tubes, conical flasks, and beakers etc. were purchased from Borosil, India.
Synthesis of Magnetic Nanoferrite particles
Fine particles were synthesized by chemical co-precipitation method 6. The separate solutions of Mg-Mn-Ni compounds (with total concentration of 0.1M) and Fe2O4 (0.2M) were prepared in 100 mL of deionized water and heated at 80°C with constant magnetic stirring until a clear solution was obtained. After stirring, the pH value was around 7. Precipitates were washed five times with demineralized water and three times with acetone. The precipitate was then calcined at 500°C for 5 hours to obtain nanoferrite particles.
Instrumentation for Characterization
X- ray diffraction patterns were taken on X’pert diffractometer using the Cu-Ka radiation at room temperature to investigate quality and structural behavior of the prepared ferrite particles. Morphological studies and chemical analyses were analyzed using FEI QUANTA 250 (SEM; Japan) with EDS. The topographical studies were taken using also with 130614 TOPOGRAPHY 045 atomic force microscopy (AFM; Bruker). Spectra analyses performed by Fourier transform infrared spectroscopy (FT-IR; PerkinElmer, MKS Technology of Productivity, Methuen, MA). Magnetic studies of the nanoferrite particles were performed using VSM (Vibrating Sample Magnetometer, Lakeshore, model 7404) with a maximum magnetic field of 20000 (G) and parameters like specific saturation magnetization (Ms), coercivity (Hc) and remanence (Mr) were evaluated.
Experimental Analyses of Antibacterial Property of Spinel Nanoferrite Particles
The antibacterial activities of the prepared ferrite particles of dissimilar concentration were tested against the pathogens like Pseudomonas fluorescens, Proteus mirablis, Staphylococcus aureus, Klebsiella pneumoniae, Escherichia coli and Enterobacter aerogenes were inoculated in nutrient broth and kept in shaker for overnight incubation. Antibacterial activities were evaluated by measuring inhibition zones. Different concentrations of synthesized ferrite particles were loaded on cotton fabrics to study their antibacterial activities by agar based diffusion method. The sterile disc with amphicillin served as positive control. The plates were incubated at 40 °C for 24 hours and inhibition zones developed around the discs was measured 7.
Materials- Bacterial Strains
The test organisms are
1. Proteus mirablis (MTCC 3310)
2. Staphylococcus aureus ( MTCC 87)
3. Enterococcus aerogenes (MTCC 111)
4. Escherichia coli (MTCC 64)
5. Klebsiella pneumoniae (MTCC 39)
6. Pseudomonas fluorescens (MTCC 103) were purchased from Institute of Microbial Technology (IMTECH) Chandigarh, India,
Synthesis of Ni Substituted Ferrite Particles Treated on Cotton Fabrics
The white cotton fabrics were hack into necessary size, washed with demineralized water and sterilized. The sterilized cotton fabrics were dried and permitted to embed with ferrite particles by immersing them in Erlenmeyer flask (300 mL) containing ferrite particles (1000 ppm) under constant stirring for 24 hours at 150 rpm. After one day the ferrite particles treated on fabrics were dried using laboratory padder and allowed to dry at 80 °C for 5 minutes in hot air oven. The well dispersed cotton fabrics were developed at 160 °C for 4 minutes for curing and stored at room temperature 8, 9.
Antibacterial Activities of Ni Substituted Ferrite Particles Treated On Cotton Fabrics
To study the antibacterial activities of ferrite particles treated on cotton fabrics, agar based diffusion method was performed 8, 9. Ferrite particles treated on cotton fabrics (10 mm × 10 mm) were used. The selected Gram positive (Staphylococcus aureus, Bacillus subtilis, Streptococcus sp.) and Gram negative (Escherichia coli, Proteus mirablis, Klebsiella pneumonia) bacterial pathogens were inoculated in sterile nutrient broth and incubated at 40 °C for 24 hours. The plates were incubated for 24 hours at 40 °C and then zone of inhibition around the fabrics was recorded.
Effect of Washing on The Antibacterial Activities of Ni Substituted Ferrite Particles
The ferrite particles treated on cotton fabrics were evaluated for their antibacterial activities before and after washing. Ferrite particles coated and uncoated fabrics have taken separately in 3000 mL sterile Schott Duran flasks and added with 1 mL of overnight grown bacterial suspension. After complete dispersion cotton fabrics were transferred to nutrient broth and incubated in rotary shaker at 150 rpm. After 24 hours incubation, 1 mL of broth from both the treated and untreated on fabrics was collected serially diluted (up to 10-7 dilution) and spread plated on nutrient agar (NA) plates. After one day incubation, the NA plates were examined for the enlargement of bacterial colonies. From that the percentage reduction of each bacterium was calculated using the formulae: PR = (100(B-A)) / B, …(1)
where PR is the Percentage reduction (%); B is the total number of bacteria recovered from untreated on fabrics; A is the total number of bacteria recovered from nanoferrite particles treated on fabrics. The wash durability of ferrite particles treated on cotton fabrics was evaluated after 5, 10 and 15 wash cycles using neutral soap (5% Hiclean, HiMedia) at 40 ± 2°C for 45 minutes with a material to liquid ratio of 1:50. After 45 minutes the fabrics were rinsed, dried and this procedure was repeated up to 15 wash cycles.
Results and Discussion-Characterization Studies For Nanoferrite Particles
XRD
XRD Patterns were analyzed and indexed using powder X Software and used to characterize the crystallinity of ferrite particles. The diffraction patterns confirmed the formation of cubic spinel structure of the prepared ferrite particles. The strongest reflection comes from the (311) plane denoted the spinel phase Figure 1. The values of crystallite size D were measured by measuring FWHM of most intense peak (311) employing Scherrer’s formula as follows: Davg=Kl/B Cosq, …(2) where K=0.89, the wave length of Cu-Ka radiation. The X-ray density (ρx-ray), measured density (ρm) and porosity (P) were also calculated using the following formulas 10. The lattice parameter values as deduced from the X-ray data are given in Table 1. From these calculated values we observed that the lattice constant (a) initially decreases and then increases with the increase in x = 0.15 and decreased from 8.332 Å to 8.223 Å. This increase could be also attributed to the substitution of the small sized Ni cation for the large sized Mn cation. Similarly average crystallite size (Davg) decreases and then increases with the increase in x = 0.15 content as 14.25 nm to 9.50 nm. It was in good agreement with several other studies where larger metal ions have been substituted with relatively smaller metal ions 11.
Table 1. Average crystallite size and Lattice parameters of the ferrite particles| Compositions (x) | D avg (nm) | a (Å) | ρ x-ray (X-ray density) | ρ m ( measured density) | Porosity (%) |
| 0.05 | 9.52 | 8.415 | 5.85 | 4.41 | 23.98 |
| 0.15 | 14.25 | 8.433 | 5.81 | 4.38 | 24.63 |
| 0.25 | 11.39 | 8.432 | 5.82 | 4.39 | 24.65 |
| 0.45 | 9.50 | 8.422 | 5.84 | 4.40 | 24.66 |
X-ray diffraction patterns gave the information of crystalline region only. The morphological studies of SEM and AFM explained the complete picture of ferrite particles. The SEM images analyzed the surface morphology, and grain size for the prepared samples is shown in Figure 2a. It was observed that the image was uniformly distributed and less agglomerated, homogenous spherical particles.
The EDS patterns getting for all the samples which have been given the elemental% and atomic% compositions and the elements detected in all the samples were O, Fe, Ni, Cu, Mg, Mn (Figure 2b).
Figure 1.The indexed XRD patterns of the Mg0.45Mn0.55−xNixFe2O4 (0.00 ≤ x ≤ 0.55) ferrite particles
Figure 2a.SEM micrographs for Mg0.45Mn0.55−xNixFe2O4 (0.00 ≤ x ≤ 0.55) ferrite particles
Figure 2b.EDS patterns for Mg0.45Mn0.55−xNixFe2O4 (0.00 ≤ x ≤ 0.55) ferrite particles
AFM
The morphology of the prepared ferrite particles was analyzed by atomic force microscopy and found to have spherical shape and size of 20 nm to50 nm well in agreement with SEM data and exhibited a spherical shape of ferrite particles as observed using noncontact mode AFM, and the two dimensional view 2D view of all the ferrite particles reveals uniform size and shape as indicated in Figure 3.
Figure 3.AFM topographic images of Mg0.45Mn0.55−xNixFe2O4 (0.00 ≤ x ≤ 0.55) ferrite particles
Spectral Measurements
The FTIR spectra for ferrite particles are shown in Figure 4. It provides valuable information regarding the nature of the functional group attached to the metal ions. The significant peaks were recorded in the range of 4000 cm-1 to 400 cm-1.
Figure 4.FTIR spectra for Mg0.45Mn0.55−xNixFe2O4 (0.00 ≤ x ≤ 0.55) ferrite particles
The low-frequency peak (ʋ2) attributed to the distribution of cations and anions on tetrahedral lattice sites, where as the high frequency peak (ʋ1) was attributed to the distribution of cations and anions on octahedral sites 12. This was assigned to the octahedral metal atom stretching vibrations. From these we observed that Mg2+, Mn2+, and Fe3+ ions can occupy both octahedral and tetrahedral sites, and Ni2+ ions can occupy octahedral site. This is due to the atomic mass and ionic radii of the ions, Mg2+ (M = 24.30 amu; r = 0.72 Å), Mn2+ (M = 54.93801 amu; r = 0.89 Å), Ni2+ (M = 58.69 amu; r = 0.69 Å) and Fe3+ (M = 55.847 amu; r = 0.64 Å). Important FT-IR bands of the ferrite particles along with their possible assignments were shown on Table 2.
Table 2. Important FT-IR bands of the nanoferrite particles along with their possible assignments| Composition | Observed wave number | Transmittance/% |
| 0.05 | 3,330.42 | 4 |
| 0.15 | 3,400.27 | 4 |
| 0.25 | 3,450.25 | 12 |
| 0.45 | 3,500.26 | 15 |
Magnetic Measurements
Magnetic properties of the prepared ferrite particles were studied by Vibrating Sample Magnetometer. In the cubic system, the magnetic order is mainly due to a super exchange interaction mechanism occurring amid the metal ions in the A and B sub lattices. Ferrite particles show low coercivity and low remanence proves that the particles are super paramagnetic behaviour 13, 14. Figure 5 shows the variation of magnetization M (emu/g) versus the applied magnetic field H (Oe) at room temperature for the prepared spinel nano ferrite particles Mn0.45Mg0.55−xNixFe2O4. All the curves appear to behave normally. The prepared samples exhibit a clear magnetic behaviour under applied magnetic field. It is evident from the results given in Table 3 that saturation magnetization, Ms and remanence, Mr increase from 8 emu/g to 23 emu/g and 1.40 emu/g to 3.02 emu/g, respectively, as Mn concentration decreased which can be explained on the basis of Neel’s theory 15.
Figure 5.Magnetic hysteresis curves for Mg0.45Mn0.55−xNixFe2O4 (0.00 ≤ x ≤ 0.55) ferrite particles
| Magnetic Parameters | Compositions (x) | |||
| x=0.05 | x=0.15 | x=0.25 | x=0.45 | |
| H c ( Oe ) | 405 | 253 | 214 | 198 |
| M r (emu/g) | 1.40 | 1.71 | 2.31 | 2.78 |
| M s (emu/g) | 8 | 11 | 16 | 21 |
| Squareness Ratio (R= M r / M s ) | 0.175 | 0.155 | 0.144 | 0.132 |
The decrement of squareness indicated that a significant amount of ferrite particles are still superparamagnetically fast relaxing at room temperature, when the external magnetic field is turned. The reduced values of the Mr/Ms ratio show powder ferrite behaviour, within the magnetization field, closer to the super paramagnetic one 16.
Results and Discussion - Studies of Antibacterial Activities of Ferrite Particles on Cotton Fabrics
SEM with EDS-Characterization Studies of Ferrite Particles
The surface morphology of MgMnNiFe2O4 ferrite particles treated and untreated on cotton fabrics were studied using electron microscopy.
The treated and untreated on fabrics were analyzed using FESEM equipped with EDS as shown in Figure 6 (a, b & c) and Figure 7 (a, b & c). The SEM images of unloaded cotton fabric showed smooth surface whereas Mg0.45Mn0.55-xNixFe2O4 (x=0.40) nanoferrite particles loaded cotton fabric showed rough surface [Figure 6 and Figure 7].
Similar to this present finding, Balakumaran et al. 17 have observed well dispersed silver ferrite particles in silver ferrite particles coated fabrics. The EDS spectrum of ferrite particles coated fabric showed strong peaks at ferrite region, confirming the successful immobilization of ferrite particles into cotton fabrics [Figure 7].
Figure 6.Scanning electron microscope analysis of unloaded cotton fabrics (a & b) Scanning electron micrographs of unloaded cotton fabric showing smooth surface; (c) EDS spectrum of unloaded cotton fabric showing no strong peaks
Figure 7.Scanning electron microscope analysis of Mg0.45Mn0.55−xNixFe2O4 (0.00 ≤ x ≤ 0.55) ferrite particles loaded cotton fabrics (a & b) Mg0.45Mn0.55−xNixFe2O4 (0.00 ≤ x ≤ 0.55) ferrite particles loaded cotton fabrics showing rough surface; (c) EDS spectrum of Mg0.45Mn0.55−xNixFe2O4 (0.00 ≤ x ≤ 0.55) ferrite particles loaded cotton fabric showing strong peaks of ferrites
Properties Analyses
Disc Diffusion Route- Antibacterial Activities of Particles (With Various Concentrations) Treated on Cotton Fabrics
Disc diffusion technique was used to study the antibacterial activities of ferrite particles against pathogens at different concentrations like 25 µg/ml, 50 µg/ml, 75 µg/ml and 100 µg/ml by measuring the zone of inhibition. The prepared ferrite particles showed greater inhibitory activity against all the experimental strains with 50 µg/ml and above concentrations are shown in Figure 8 and Table 4. Above all, the pathogenic strain, Staphylococcus aureus was found to be more vulnerable to the synthesized nanoferrite particles. Next to Staphylococcus aureus, the ferrite particles inhibited the growth of Enterococcus aerogenes, Escherichia coli and Proteus mirabilis in a vital manner. The ferrite particles were found to be least toxic towards Klebsiella pneumoniae and Pseudomonas fluorescens. Thus indicating that the biologically synthesized ferrite particles were found to be possessing better antibacterial activities towards all the human pathogenic bacteria tested.
Table 4. Antibacterial activities of MgMnNiFe2O4 ferrite particles| Organism | Antibacterial activities (Zone of inhibition in mm) | |||
| 25 µg/ml | 50 µg/ml | 75 µg/ml | 100 µg/ml | |
| Proteus mirablis | - | 1.3 | 1.8 | 1.9 |
| Staphylococcus aureus | - | 1.8 | 1.9 | 2.0 |
| Enterococcus aerogenes | - | 1.6 | 1.7 | 2.4 |
| Escherichia coli | - | 1.4 | 1.8 | 2.2 |
| Klebsiella pneumoniae | - | 1.0 | 1.4 | 1.7 |
| Pseudomonas fluorescens | - | 0.8 | 1.5 | 1.8 |
Figure 8.Antibacterial activities of Mg0.45Mn0.55−xNixFe2O4 (0.00 ≤ x ≤ 0.55) ferrite particles for various concentrations
Figure 8a.Antibacterial responses in terms of inhibition zone (in mm)
Above all, the pathogenic strain, Staphylococcus aureus was found to be more vulnerable to the synthesized nanoferrite particles. Next to Staphylococcus aureus, the nanoparticles inhibited the growth of Enterococcus aerogenes, Escherichia coli and Proteus mirabilis in a vital manner. The nanoferrite particles were found to be least toxic towards Klebsiella pneumoniae and Pseudomonas fluorescens. Thus indicating that the biologically synthesized ferrite particles were found to be possessing better antibacterial activities towards all the human pathogenic bacteria tested.
The main plan of the study is to test whether the ferrite particles could report antimicrobial activities to cotton fabrics or not. About 150 ppm of ferrite particles was coated in each cotton fabric using pad-dry-cure method and the fabrics were assessed for their antibacterial activities using typical procedure. In agar diffusion technique nanoferrite particles treated on cotton fabrics exhibited remarkable antibacterial activities against six different human pathogenic bacteria. Thus, it is evident that the present research shows better antibacterial activities as inhibition zone was found to be higher than previous reports 17, 18. The possible system for antibacterial activities of ferrite particles treated on cotton fabrics was probably owing to the formation of chemical bond among the functional groups of ferrite particles and the functional groups of the textile substrates and also the physical adsorption of the prepared particles on the surface of the fabrics 19. It is obvious from the Table 4 that antibacterial activity of the zone of inhibition = 100 µg/ml is found to be higher against both Gram positive and negative bacteria than those of other concentrations. However lesser activity is recorded on Pseudomonas fluorescens.
The responses of antibacterial activities are depicted in Figure 8a. Hence this laboratory is found to report antibacterial property of a few chosen bimetallic ferrite particles at definite ratios (for ex., x=0.40). The smaller fine ferrite particles have the greater surface area to volume ratio. This enhances their biological and chemical activity by raising the contact area of the bimetal with a microorganism. The use of nanoscale bimetals allows achieving hundred time decreased concentration and at the same time increase in antimicrobial properties.
Ager Diffusion Method-Antibacterial Activities of Ferrite Particles (With Coated and Uncoated) On Cotton Fabrics
The antibacterial properties of ferrite particles treated on cotton fabrics were evaluated against selected Gram positive and Gram negative bacteria. The antibacterial efficiency of the prepared nanoferrite particles treated on cotton fabrics was studied using agar diffusion assay and the results were shown in Figure 9. The nanoferrite particles treated on fabrics displayed good antibacterial activities with a clear zone of inhibition around the cotton fabrics against all the tested pathogens; however the untreated (control) on fabrics did not show any inhibition zone.
Figure 9.Antibacterial activities on cotton fabrics with coated and uncoated Mg0.45Mn0.55−xNixFe2O4 (0.00 ≤ x ≤ 0.55) ferrite particles
These results specify that an increase in nanoferrite particles concentration generates strong antibacterial activity toward the tested pathogens. It shows that the antibacterial activity of the nanomaterials increased with increase in surface-to-volume ratio owing to the decrease in size of nanoferrite particles. Furthermore preceding studies have indicated that the smaller ferrite particle size, the greater the efficacy in inhibiting the growth of bacteria than other’s reports 20, 21, 22. Conversely the prepared ferrite particles were formerly reported to act both as bactericidal agent and also bacteriostatic agent possibly thereby limiting their biomedical use.
Further investigations are required for substantial increase of antibacterial characteristics of ferrite particles by modulating the molar ratios of them considering their applied use in pharmaco- therapeutic industry and nanodrug delivery system.
Effect of Washing on The Antibacterial Activities of Mgmnnife2o4 Nanoferrite Particles Loaded on Cotton Fabrics
The antibacterial activities of ferrite particles loaded on cotton fabrics were carried out before and after numerous wash cycles. The prepared ferrite particles treacted on cotton fabrics depicted tremendous laundering stability with pronounced antibacterial activities even after 15 wash cycles. The percentage of inhibition of bacteria was found to be decreased with increasing of wash cycles from 5 to 15 Table 5.
Table 5. Effect of wash cycles on antibacterial activities of cotton fabrics loaded with Mg0.45Mn0.55−xNixFe2O4 (0.00 ≤ x ≤ 0.55) ferrite particles| Organism | Antibacterial activity (Reduction percentage %) | |||
| Before washing | After 5 washes | After 10 washes | After 15 washes | |
| Proteus mirablis | 99.81 | 98.63 | 96.13 | 94.32 |
| Staphylococcus aureus | 99.52 | 98.54 | 96.11 | 94.43 |
| Enterococcus aerogenes | 99.78 | 98.85 | 96.34 | 94.87 |
| Escherichia coli | 99.37 | 98.78 | 96.14 | 95.53 |
| Klebsiella pneumonia | 99.45 | 98.76 | 96.17 | 95.02 |
| Pseudomonas fluorescens | 99.12 | 97.76 | 95.23 | 92.98 |
In the present investigation we observed more reduction of bacterial colonies irrespective of the concentration of ferrite particles content of the fabrics than that of others. In an earlier studies 23, 24 they observed nearly 50% loss of antibacterial activities after 20 wash cycles whereas we observed that after 15 cycles and this present study suggested the use of binder or cross linker to improve the durability of the fabrics. The reduction of bacterial colonies irrespective of the concentration of ferrite particles on fabrics is much higher than that of the other reports 23, 24.
Conclusion
In the present research a simplistic approach was used to synthesize ferrite particles on cotton fabrics in order to obtain finished fabrics; it is very significant in biological applications. The results on the investigations of the nanoferrite particles demonstrate that these particles inhibited the growth of bacteria at very low concentrations. The influence of these ferrite particles and morphology of the nanostructure is significant for the antimicrobial activity of the prepared particles which is important for textile industries. Also these nanoferrite particles treated on fabrics showed tremendous laundering sturdiness as well distinct antibacterial activity even after 15 wash cycles. Thus, the application of these ferrite particles as antibacterial agent will be very precious for biomedical and industrial applications. This application can also be extended to produce ferrite particles embedded antiseptic dressing or bandage for medical purposes in the future.
Acknowledgement
The authors are thankful to Dr. K P Singh, Department of Zoology at University of Allahabad for useful discussion. Medical laboratory in-charge Dr. Patel, Green Cross Pathology and Molecular Laboratory, Paldi in Ahmedabad is acknowledged for skilled technical assistance. One of the authors Dr.S. R. Chitra gratefully acknowledges DST (Ref. no SERC no. 100/IFD/7194/2010-11 dated 12.10.10) and also UGC for the financial assistance received through the project.
References
- 1.Shahzeidi Z S, Amiri Gh. (2015) Antibacterial activity of Fe3O4nanoparticles. , Int. J. Bio-Inorg. Hybr. Nanomater 4(3), 135-140.
- 2.Katerina. (2009) Superparamagnetic maghemite nanoparticles from solid-state synthesis – Their functionalization towards peroral MRI contrast agent and magnetic carrier for tryps in immobilization. , Biomaterials 30(15), 2855-2863.
- 3.Vishal. (2016) Synthesis and characterization of nickel cobalt ferrite nanoparticles via heat treatment method. Advance Materials Proceedings 1(1), 76-80.
- 4.Wu Wei. (2008) Quanguo He and Changzhong Jiang, Magnetic Iron Oxide Nanoparticles: Synthesis and Surface Functionalization Strategies, Nanoscale Res. , Lett 3, 397-415.
- 6.Subbiah Rammohan Chitra, Sendhilnathan Sechasalom. (2015) Structural and Electrical Properties of Ni-Substituted Mg-Mn Nanoferrite by Coprecipitation Route’. , Int. J. Appl. Ceram. Technol 12(3), 643-651.
- 7.El-Rafie. (2010) Antimicrobial effect of silver nanoparticles produced by fungal process on cotton fabrics. , Carbohydr. Polym 80, 779-782.
- 8.Rajendran. (2011) Dyeing and antimicrobial properties of cotton fabrics finished with Punica granatum extracts. , J. Text. Appar. Technol. Manag 7, 1-12.
- 9.Deraz N M, Omar H, Elkader Abd. (2013) Preparation and characterization of nano-magnetic Ni0.5Mg0.5Fe2O4system for Biological applications. , J. pure Appl. Microbiol 7, 339.
- 10.Das A R, Ananthan V S, Khan D C. (1985) Wall permeability studies on Ti4+doped Ni-Zn ferrite. , J. Appl. Phys 57, 4189.
- 11.Vinuthna C, Ravinder D, Madhusudan R. (2013) Characterization of Co1-XZnxFe2O4nano spinal ferrites prepared by citrate precursor method. , Int. Journal of Engineering Research and Applications 3(6), 654-660.
- 12.Pathan A T, Shaikh A M. (2012) Synthesis and characterization of cobalt substituted Li-Ni-Zn nano ferrites by chemical route. , European Journal of Applied Engineering and Scientific Research 1(4), 173-178.
- 13.Duque. (2007) Magnetic properties of NiFe2O4nanoparticles produced by a new chemical method. , Physica B 398, 287-290.
- 14.Kneller E F, Hawig R. (1991) The Exchange-Spring Magnet: A New Material Principle for Permanent Magnets. , J. Magn. Magn. Mater 27, 3588-3560.
- 16.Jacobo S E, Uhalde S D, Bertorello H R. (2004) Rare Earth influence on the structural and magnetic properties of NiZn ferrites. , J. Magn. Magn. Mater 272, 2253-2254.
- 17.Balakumaran. (2016) In vitro biological properties and characterization of nanosilver coated cotton fabrics: An application for antimicrobial textile finishing. , Int. Biodeter. Biodegrad 107, 48-55.
- 18.Sathianarayanan. (2010) Antibacterial finish for cotton fabric from herbal products. , Indian J. Fibre Textile Res 35, 50-58.
- 19.Perelshtein. (2009) Sonochemical coating of silver nanoparticles on textile fabrics (nylon, polyester and cotton) and their antibacterial activity. , Nanotechnol 19, 245705.
- 20.Raghupati K R, Koodali R T, Manna A C. (2011) Size-dependent bacterial growth inhibition and mechanism of antibacterial activity of zinc oxide nanoparticles. , Langmuir 27, 4020-4028.
- 21.Mahapatra. (2008) Ultrafine dispersed CuO nanoparticles and their antibacterial activity. , J. Exp Nanosci 3, 185-193.
- 22.Tran. (2010) Bactericidal effects of iron oxide nanoparticles on Staphylococcus aureus. , Int J. Nanomedicine 5, 277-283.
